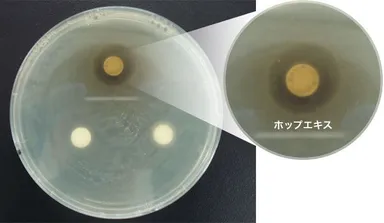
A群溶レン菌に対する各ハーブエキスの阻止円

カンロ飴や健康のど飴、ピュレグミなどでおなじみのカンロ株式会社(本社:東京都新宿区、代表取締役社長:三須和泰、以下 カンロ)は、ハーブの一種である「ホップ」が、のどの炎症を引き起こす「A群溶血レンサ球菌」(Streptococcus pyogenes、以下A群溶レン菌)に対して、123種のハーブエキスの中で最も強い殺菌力があることを確認いたしました。
カンロは、1981年に「健康のど飴」を発売し、食品菓子業界で初めて「のど飴」をご提供したのど飴のパイオニア企業です。のど飴には欠かせないハーブについて、長年にわたって研究を行ってきました。2015年に東京都江東区に「KANRO R&D 豊洲研究所」を開所した際にハーブ研究の専用環境を整備しており、ハーブに関する研究を強化した結果、この度の結果にたどり着きました。
■試験方法
<試験1>
A群溶レン菌を寒天培地に植え付けた後に123種のハーブエキスを各々ろ紙に添加しました。
37℃、5%CO2の条件下で数日培養した後に阻止円(A群溶レン菌が生育できない領域)の有無と大きさを確認しました。その結果、「ホップ」を含む11種のハーブエキスについて大きな阻止円を認め、A群溶レン菌に対する抗菌力(菌の増殖を抑制する力)が確認できました。
<試験2>
107個/mlのA群溶レン菌を試験管に入れ、試験1において抗菌力が確認された11種のハーブエキスを各自添加しました。37℃、5%CO2の条件下で数時間培養した後、A群溶レン菌の生菌数を確認しました。その結果、「ホップエキス」の殺菌力(菌を死滅させる力)が最も高いことが分かりました。

※「殺菌」菌を殺す・死滅させること
「抗菌」菌を殺したり減少させるのではなく菌の増殖を抑制、あるいは阻害すること
■「のど」炎症の仕組み
のどの炎症反応は、主に発赤(赤くなる)、熱感(熱を帯びる)、腫脹(腫れる)、疼痛(痛む)などです。この炎症は、A群溶レン菌がのどの粘膜から侵入し、侵入された生体がA群溶レン菌を排除しようとして起こります。
■「ホップ」とは
ホップはハーブの一種であり、和名を「せいようはなからそう」といい、ヨーロッパ原産のアサ科に属するつる性植物です。独特の苦みを持ち、一般的にはビールの原料として使用されています。「ホップには雑菌の繁殖を抑え、ビールの保存性を高める働きがある」ことが経験的に知られています。
■会社概要
社名 : カンロ株式会社
代表 : 代表取締役社長 三須和泰
所在地 : 東京都新宿区西新宿3丁目20番2号 東京オペラシティビル37階
創業 : 1912年(大正元年)11月10日
事業内容: 菓子、食品の製造および販売
URL : https://www.kanro.co.jp/
カンロ研究開発WEBサイト:https://www.kanro.co.jp/RandD/function/herb_extract/
当社は創業から百余年、「糖と歩む企業」として、社名になっている「カンロ飴」を始め、ミルクキャンディ売上No.1※「金のミルクキャンディ」、菓子食品業界で初となる「健康のど飴」、大人の女性に向けたグミ市場を創り上げた「ピュレグミ」など、常に消費者の皆様から愛され続ける商品を創り続けてまいりました。2012年からは直営店「ヒトツブカンロ」を運営し、「ヒトからヒトへ つながる ヒトツブ」をコンセプトにキャンディの魅力を発信しています。
※株式会社インテージSRI ミルクフレーバーキャンディ市場
2015年10月~2017年9月累計販売金額アイテムランキング















